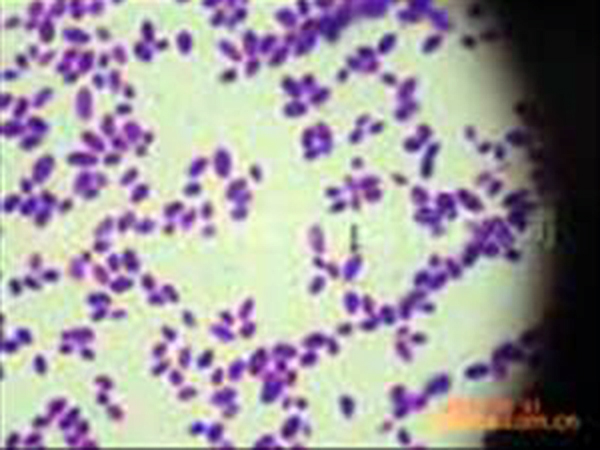
細(xì)胞生物學(xué)玻片

冰凍切片:在細(xì)胞生物學(xué)玻片標(biāo)本的放射自顯影示蹤研究中,當(dāng)遇到需要防止某些在體內(nèi)呈游離態(tài)的放射性核素發(fā)生擴(kuò)散易位或流失時(shí)。應(yīng)采用冰凍切片操作,可使用帶有冷凍干燥裝置的切片機(jī)或半導(dǎo)體冰凍切片機(jī)來制備整
冰凍切片:在細(xì)胞生物學(xué)玻片標(biāo)本的放射自顯影示蹤研究中,當(dāng)遇到需要防止某些在體內(nèi)呈游離態(tài)的放射性核素發(fā)生擴(kuò)散易位或流失時(shí)。應(yīng)采用冰凍切片操作,可使用帶有冷凍干燥裝置的切片機(jī)或半導(dǎo)體冰凍切片機(jī)來制備整體水平、臟器水平或細(xì)咆水平的各種冰凍切片標(biāo)本,在制備過程中,標(biāo)本可以不經(jīng)任何溶液處理。切片制成后。不能解凍,應(yīng)立即進(jìn)行真空冷凍干燥脫水。
石蠟切片:它適用于與體內(nèi)組織呈牢固結(jié)合態(tài)的放射性核素的放射自顯影示蹤研究??刹捎檬炃衅瑱C(jī)在常溫下進(jìn)行切片。在制備過程中,標(biāo)本必須經(jīng)固定波固定,水洗,梯度酒精脫水,二甲苯浸透和石蠟包埋等程序。在制備石蠟切片的操作過程中,可將在組織成分中呈游離態(tài)的放射性核素完全洗脫。石蠟切片得出的組織結(jié)構(gòu)的清晰度**冰凍切片。
應(yīng)該指出的是,在細(xì)胞生物學(xué)玻片標(biāo)本中,如果使用甲醛或戊二醛等醛類固定液固定組織后,應(yīng)對(duì)植物組織切片進(jìn)行充分的流水沖洗,以防止殘留的固定液對(duì)乳膠產(chǎn)生化學(xué)假像。
- 上一篇:細(xì)胞生物學(xué)和遺傳學(xué)切片
- 下一篇:染色體玻片

全國熱線電話: